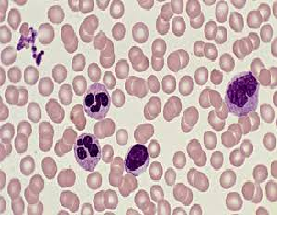

Small Animal Lab Work
We have a fully equipped in-clinic lab to help diagnose many conditions during your visit. This will lead to faster treatment and a quicker return to normal for your pet. Our in-house testing includes:
Blood Work Panels
- Snap tests such as the 4DX Heartworm and Tick Disease test, Feline Leukemia/FIV test, Parvo test, Giardia Test, and more.
- Blood chemistries to check organ function, or medication levels.
- Blood cell counts to look for anemia, infection, and/or clotting issue.
Urinalysis

Analysis of ear swabs

Skin cytology & checking for mites

Aspirates of skin masses

For more extensive or specialized testing, we can send samples to a reference laboratory. These tests typically take 1 to 3 days to receive results.
Small Animal Imaging
Sometimes, it requires a look inside to find what is troubling your pet. We have high-quality digital radiography (x-ray) capability, so we can see a tooth abscess that is under the gums, or a broken bone in the foot, or the engagement ring your dog swallowed.


Unfortunately, sometimes the problem may require more advanced imaging, so we may refer you to a specialty center for procedures like echocardiograms, abdominal ultrasounds, or CT/MRI scanning. Whatever we can do to make your pet feel better.

